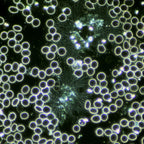
Condensator de camp inchis cardioid CDF cu LED image 2

Salt la informațiile despre produs


Condensator de camp inchis cardioid CDF cu LED
1.980,00 lei
Disponibil in rate
Condensator de camp inchis cardioid CDF cu LED